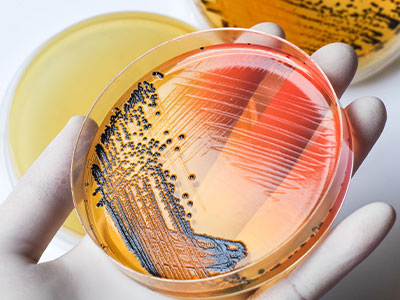
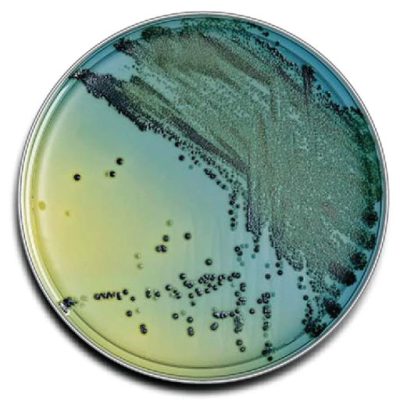
ff19da87-505c-42a8-bbd0-45186c60a179
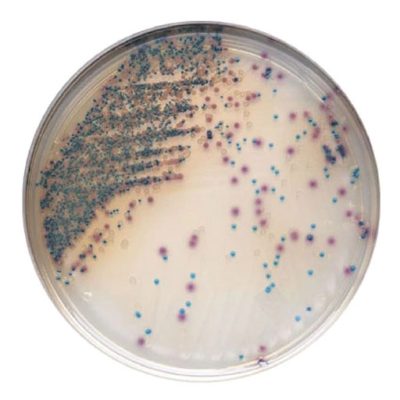
f47d14e7-bf4a-466e-a00a-fe658df0cc2a
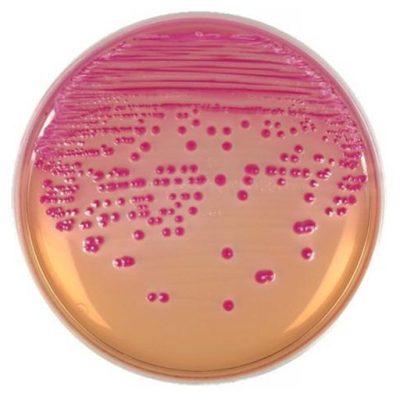
d603998e-5924-4a82-b63f-772073299e18
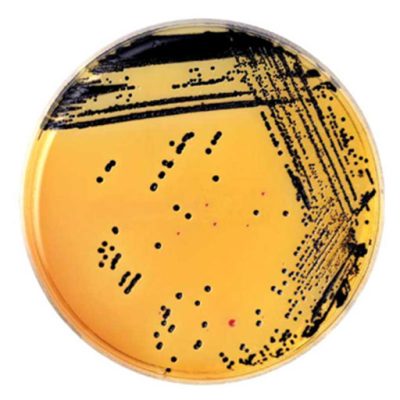
ce5cf8a1-7558-4e6c-880b-d6050c938d80
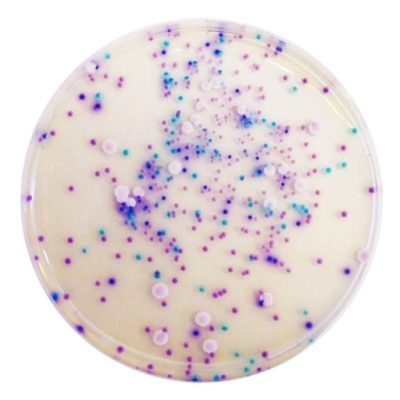
416df1a3-7306-46fb-93ed-609baa9c67a9
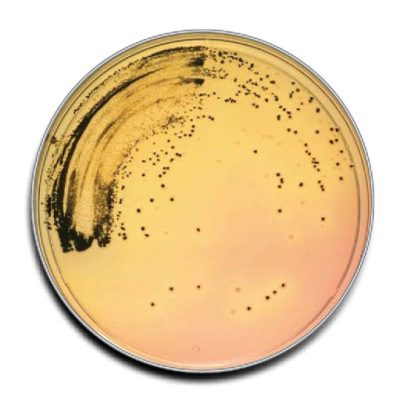
6b605317-7375-4189-aae8-562e0873653b
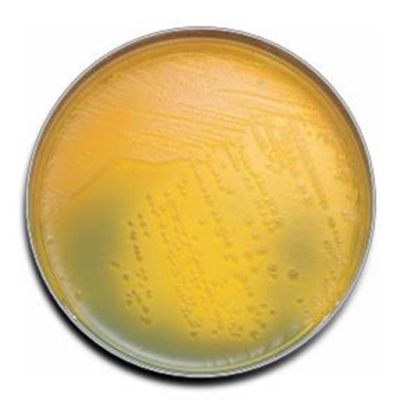
4c71dbce-328a-4b5a-99bd-679bdaef7062

محیط کشت

لوازم و تجهیزات آزمایشگاهی

دستگاه ها

مواد شیمیایی صنعتی
محیط کشت یست مولد براث ایبرسکو گرید آزمایشگاهی
197,000 تومان – 689,000 تومانمحدوده قیمت: 197,000 تومان تا 689,000 تومانمحیط کشت یست مولد آگار ایبرسکو گرید آزمایشگاهی
197,000 تومان – 689,000 تومانمحدوده قیمت: 197,000 تومان تا 689,000 تومانمحیط کشت یست اکسترکت آگار ایبرسکو گرید آزمایشگاهی
189,000 تومان – 685,000 تومانمحدوده قیمت: 189,000 تومان تا 685,000 تومانمحیط کشت یست اکسترکت ایبرسکو گرید آزمایشگاهی
235,000 تومان – 745,000 تومانمحدوده قیمت: 235,000 تومان تا 745,000 تومانمحیط کشت یرسینیا سلکتیو آگار بیس (نووبیوسین آگار ب ایبرسکو گرید آزمایشگاهی
197,000 تومان – 659,000 تومانمحدوده قیمت: 197,000 تومان تا 659,000 تومانمحیط کشت یرسینیا (CIN) آگار ایبرسکو گرید آزمایشگاهی
197,000 تومان – 689,000 تومانمحدوده قیمت: 197,000 تومان تا 689,000 تومانمحیط کشت ویولت رد بایل آگار ایبرسکو گرید آزمایشگاهی
187,000 تومان – 655,000 تومانمحدوده قیمت: 187,000 تومان تا 655,000 تومانمحیط کشت هلیکوباکتر پیلوری انتخابی مدیوم بیس ایبرسکو گرید آزمایشگاهی
235,000 تومان – 897,000 تومانمحدوده قیمت: 235,000 تومان تا 897,000 تومانمحیط کشت هکتون انتریک آگار ایبرسکو گرید آزمایشگاهی
249,000 تومان – 795,000 تومانمحدوده قیمت: 249,000 تومان تا 795,000 تومانمحیط کشت هارت اینفیوژن براث ایبرسکو گرید آزمایشگاهی
315,000 تومان – 950,000 تومانمحدوده قیمت: 315,000 تومان تا 950,000 تومانمحیط کشت هارت اینفیوژن آگار ایبرسکو گرید آزمایشگاهی
315,000 تومان – 950,000 تومانمحدوده قیمت: 315,000 تومان تا 950,000 تومانمحیط کشت نوترینت براث ایبرسکو گرید آزمایشگاهی
199,000 تومان – 695,000 تومانمحدوده قیمت: 199,000 تومان تا 695,000 تومانوبلاگ بافـــر
11
سپتامبر
سوالات متداول در مورد میکروفلوئیدیکس
۱- میکروفلوئیدیکس چیست؟
میکروفلوئیدیک علم و فناوری سیستمهایی است که با استفاده از کانالهایی با اب...
11
سپتامبر
شیمی کلیک چیست و چرا برنده جایزه نوبل شد؟
درسی از طبیعت: شیمی کلیک چیست و چرا برنده جایزه نوبل شد؟
واکنش شیمیایی خاصی وجود دارد که اغلب به آ...
31
جولای
پدر اپیدمیولوژی مدرن
تولد و تحصیلات
جان اسنو در 15 مارس 1813 در یورک انگلستان به عنوان اولین فرزند خانواده به دنیا آ...
28
جولای
تاثیر علوم محاسباتی در رشد علوم پایه و مهندسی
علوم محاسباتی و نرمافزارهای محاسباتی نقش مهمی در پیشرفت علوم پایه ایفا کرده و احتمالاً در آینده نیز...
20
جولای
ابزارها و تجهیزات مهم شیمیدانها
شیمیدانها به طور عمده با ابزارها و تجهیزات مختلف در آزمایشگاه کار میکنند تا اندازهگیریها و تسته...